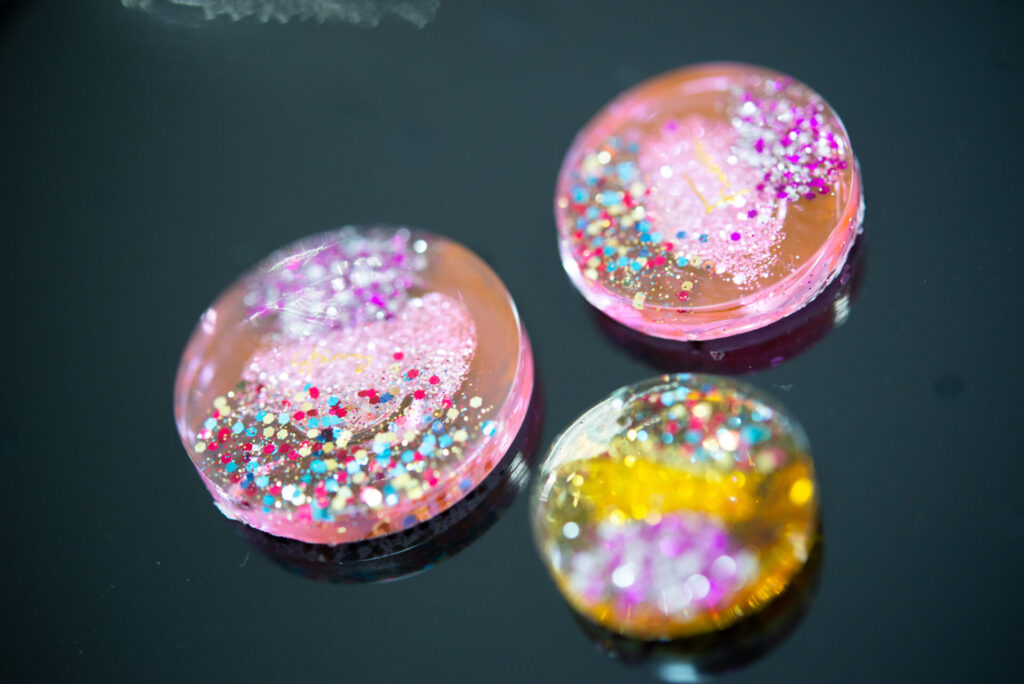

こんにちは!
当事業所で初期から作成しております、レジン製品の新作が出来上がりました。
レジンは紫外線で固まる特殊な性質で、様々な世界観を1つの作品に織り込む事が出来、
ハンドメイドでも人気のあるジャンルになります!
今回はレジンの新しい作品をご紹介します。
新作続々 レジン作品

キーホルダーのストラップなどをつけると、カバンなどに気軽につけることができます。
今回はラメ入りのキラキラとしたデザインの新作が多数!
固まる工程で入った気泡もまた美しく、
アイディア次第で色々な表情を見せてくれるのがレジンの凄いところですね!
見学・体験いつでも大歓迎です!
更に詳しい情報は下のボタンのリンク先(元気さーち)
にて記載がありますので、是非ご閲覧ください!
事業所での作品販売も行っております!

事業所内での作品の販売を行っております。
イベント出店以外でもたっちの作品をお買い求め頂けますので、
ご興味のある方は下記電話番号・InstagramのDMまでお気軽にご連絡ください!
お問い合わせ
電話でのお問い合わせは
コチラ
TEL:011-375-1335
受付時間 平日9:00~16:00
「ホームページを見ました」等を
お伝えいただけますと
スムーズにお話が進みます!

InstagramのDMでお問い合わせ
上記のリンクをタップ
もしくは
QRコードからアカウントにアクセス
もしくは
@tatti_b212 で検索をお願いします!












